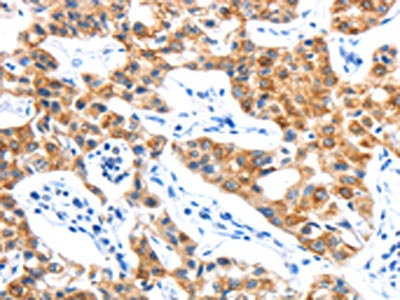

LYVE1 Antibody
-
中文名稱:LYVE1兔多克隆抗體
-
貨號:CSB-PA915341
-
規格:¥1100
-
圖片:
-
The image on the left is immunohistochemistry of paraffin-embedded Human lung cancer tissue using CSB-PA915341(LYVE1 Antibody) at dilution 1/15, on the right is treated with fusion protein. (Original magnification: ×200)
-
The image on the left is immunohistochemistry of paraffin-embedded Human gastic cancer tissue using CSB-PA915341(LYVE1 Antibody) at dilution 1/15, on the right is treated with fusion protein. (Original magnification: ×200)
-
Gel: 10%SDS-PAGE, Lysate: 50 μg, Lane: Mouse liver tissue, Primary antibody: CSB-PA915341(LYVE1 Antibody) at dilution 1/300, Secondary antibody: Goat anti rabbit IgG at 1/8000 dilution, Exposure time: 20 seconds
-
-
其他:
產品詳情
-
Uniprot No.:
-
基因名:
-
別名:Cell surface retention sequence-binding protein 1 antibody; CRSBP 1 antibody; CRSBP-1 antibody; CRSBP1 antibody; extracellular link domain containing 1 antibody; extracellular link domain-containing 1 antibody; Extracellular link domain-containing protein 1 antibody; HAR antibody; Hyaluronic acid receptor antibody; Lymphatic endothelium specific hyaluronan receptor antibody; lymphatic vessel endothelial hyaluronan receptor 1 antibody; Lymphatic vessel endothelial hyaluronic acid receptor 1 antibody; LYVE 1 antibody; LYVE-1 antibody; LYVE1 antibody; LYVE1_HUMAN antibody; XLKD1 antibody
-
宿主:Rabbit
-
反應種屬:Human,Mouse
-
免疫原:Fusion protein of Human LYVE1
-
免疫原種屬:Homo sapiens (Human)
-
標記方式:Non-conjugated
-
抗體亞型:IgG
-
純化方式:Antigen affinity purification
-
濃度:It differs from different batches. Please contact us to confirm it.
-
保存緩沖液:-20°C, pH7.4 PBS, 0.05% NaN3, 40% Glycerol
-
產品提供形式:Liquid
-
應用范圍:ELISA,WB,IHC
-
推薦稀釋比:
Application Recommended Dilution ELISA 1:1000-1:2000 WB 1:200-1:1000 IHC 1:15-1:50 -
Protocols:
-
儲存條件:Upon receipt, store at -20°C or -80°C. Avoid repeated freeze.
-
貨期:Basically, we can dispatch the products out in 1-3 working days after receiving your orders. Delivery time maybe differs from different purchasing way or location, please kindly consult your local distributors for specific delivery time.
-
用途:For Research Use Only. Not for use in diagnostic or therapeutic procedures.
相關產品
靶點詳情
-
功能:Ligand-specific transporter trafficking between intracellular organelles (TGN) and the plasma membrane. Plays a role in autocrine regulation of cell growth mediated by growth regulators containing cell surface retention sequence binding (CRS). May act as a hyaluronan (HA) transporter, either mediating its uptake for catabolism within lymphatic endothelial cells themselves, or its transport into the lumen of afferent lymphatic vessels for subsequent re-uptake and degradation in lymph nodes.
-
基因功能參考文獻:
- LYVE1 was up-regulated in the malignant Middle Cerebral Artery Infarction. PMID: 28828208
- this study shows up-regulation of LYVE-1 expression in the fetal circulation of conducting and exchange villi of HIV-infected pre-eclamptics PMID: 27529307
- Dendritic cells (DCs) docked to the basolateral surface of lymphatic vessels and transited to the lumen through hyaluronan-mediated interactions with the lymph-specific endothelial receptor LYVE-1. Targeted deletion of the gene Lyve1, antibody blockade or depletion of the DC hyaluronan coat not only delayed lymphatic trafficking of dermal DCs but also blunted their capacity to prime CD8(+) T cell responses in LNs. PMID: 28504698
- These findings reveal binding is dependent not just on clustering but also on the biochemical properties of LYVE-1 homodimers. They also mark LYVE-1 as the first Link protein superfamily member requiring covalent homodimerization for function and suggest the interchain disulfide acts as a redox switch in vivo. PMID: 27733683
- LYVE1 expression is significantly upregulated in human masticatory mucosa during wound healing PMID: 28005267
- Immunostaining analyses in psoriasis skin lesions suggested that the ectodomain shedding of LYVE-1 occurred in lymphatic vessels undergoing chronic inflammation. These results indicate that the ectodomain shedding of LYVE-1 might be involved in promoting pathological lymphangiogenesis. PMID: 26966180
- These results demonstrate the prerequisite of a critical LYVE-1 threshold density and show that hyaluronan binding may be elicited in lymphatic endothelium by surface clustering with divalent LYVE-1 mAbs. PMID: 26823460
- We have established a novel, three-protein biomarker panel that is able to detect patients with early-stage pancreatic cancer in urine specimens:LYVE-1, REG1A, and TFF1 were selected as candidate biomarkers PMID: 26240291
- Data (including data from studies in knockout mice) suggest LYVE1 mediates adhesion of group A Streptococci (GAS) to lymphatic vesicular endothelium via capsular hyaluronan; this appears to be critical factor for lymphatic trafficking of GAS in vivo. PMID: 26352587
- High expression of LYVE-1 is associated with atherosclerotic arteries. PMID: 25318003
- High LYVE expression is associated with visceral pleural invasion and lymphatic thromboembolism in non-small-cell lung cancer. PMID: 25141859
- Data indicate that detection of lymphatic vascular invasion (LVI) can be optimized by specific D2-40 or LYVE-1 staining. PMID: 21974896
- High-low cell surface HA content of tumor cells through the interaction with LYVE-1 leads to adhesion differences. PMID: 23717428
- FGF2 binds to LYVE-1 with a higher affinity than any other known LYVE-1-binding molecules, such as hyaluronan or PDGF-BB. Glycosylation of LYVE-1 is important for FGF2 binding. PMID: 23264596
- CRSBP-1-associated fibrillar structures are identical to the ER network as evidenced by the co-localization of CRSBP-1 and BiP in these cells PMID: 22673514
- LYVE-1 may have value as predictor of outcome in neuroblastoma PMID: 22241180
- Significant correlation between LYVE-1 and Prox-1 expression was observed in non-small cell lung cancer. Expression was also correlated with lymph node metastasis. PMID: 21500548
- LYVE-1, VEGFR-3 and CD44 all play an important role in lymphangiogenesis, invasion and metastasis PMID: 21912471
- these data support interdependent roles for emmprin, LYVE-1 and BCRP in chemotherapeutic resistance for PEL PMID: 21660043
- Results suggest that LYVE-1 allows the adhesion of tumor cells through the interaction of HA on the tumor cell membrane with LYVE-1. PMID: 21291635
- Intratumoral lymph vessel density marked by LYVE-1 in laryngeal carcinoma was significantly correlated with tumor infiltration and metastasis. PMID: 17144490
- Data show that the density of LYVE-1/+ capillaries in skeletal muscle was observed to decrease significantly over the time course of the exercise intervention. PMID: 20863269
- findings indicated that LYVE-1 attenuation in sinusoidal endothelium was one of the manifestations of capillarization, and was associated with hepatic disease progression PMID: 19908110
- LYVE-1 indicates an increase of lymphangiogenesis in colorectal carcinoma. PMID: 19742347
- A study using specific markers of endothelium (CD31) and lymphatic endothelial cells (Lyve-1, Podoplanin) shows that not only angiogenesis but also lymphangiogenesis occurs within the nodule. PMID: 20011036
- new approach measuring lymphangiogenesis using LYVE-1, a novel, specific lymphatic marker in breast cancer tissue PMID: 11689016
- LYVE-1 is not exclusive to the lymph vessels PMID: 11719431
- LYVE-1 does not seem to be a reliable marker for proliferating infantile hemangiomas. PMID: 16424896
- findings indicate (1) the importance of LYVE-1, but not CD44, in regulation of HA metabolism in the maternal-fetal interface and fetal circulation, and (2) possible dual blood and lymphatic phenotypic characteristics in fetal endothelium PMID: 16569201
- Molecular data based on gene transcriptional profiles of a 3-gene set (GPC3, LYVE1, and survivin) allow a reliable diagnosis of early hepatocellular carcinoma. PMID: 17087938
- analysis of inflammation-induced uptake and degradation of the lymphatic endothelial hyaluronan receptor LYVE-1 PMID: 17884820
- DC-sign+ CD163+ macrophages expressing hyaluronan receptor LYVE-1 are located within chorion villi of the placenta. PMID: 18078989
- Presence of LYVE-1 in pancreatic islets and in some pancreatic endocrine tumors may suggest structure-function relationship of LYVE-1/lymphatic vessel in hormone synthesis and secretion. PMID: 18090227
- LYVE-1 immunohistochemistry appeared to be a useful method for detecting lymphatics invaded by cancer cells, and detailed examination of the submucosa around the tumor may be important for predicting LN metastasis. PMID: 18181096
- LYVE-1 expression and the lymphatic density of the muscularis propria are significantly greater than those of other layers of urothelium, including the epithelium, lamina propria, perivesical fat, and serosa PMID: 18342921
- LYVE-1 is expressed in a reticulum cell neoplasm in an axillary lymph node. This reticulum cell sarcoma is a lymphatic sinus lining cell sarcoma which might represent another subtype of reticulum cell sarcomas. PMID: 18386053
- The normal adult human choroid does not contain typical lymph vessels, but is endowed with a significant number of LYVE-1 positive macrophages. PMID: 18689706
- complexity in the regulation of LYVE-1 function and raise the possibility that this receptor, like CD44, may become active after appropriate unmasking in vivo. PMID: 19033446
- LYVE-1 immunostaining in some gastrointestinal carcinoids may support a structure-function relationship of lymphatic vessels/hyaluronan receptor for modulating synthesis and secretion of hormones and amines by carcinoid tumour cells. PMID: 19291537
- CRSBP-1 exhibits dual ligand (CRS-containing growth regulators (v-sis gene product and insulin-like growth factor binding protein-3, IGFBP-3) and hyaluronic acid) binding activity and plays a role in autocrine regulation of cell growth. PMID: 12912978
顯示更多
收起更多
-
亞細胞定位:Membrane; Single-pass type I membrane protein. Note=Localized to the plasma membrane and in vesicles near extranuclear membranes which may represent trans-Golgi network (TGN) and endosomes/prelysosomeal compartments. Undergoes ligand-dependent internalization and recycling at the cell surface.
-
組織特異性:Mainly expressed in endothelial cells lining lymphatic vessels.
-
數據庫鏈接:
Most popular with customers
-
-
YWHAB Recombinant Monoclonal Antibody
Applications: ELISA, WB, IHC, IF, FC
Species Reactivity: Human, Mouse, Rat
-
Phospho-YAP1 (S127) Recombinant Monoclonal Antibody
Applications: ELISA, WB, IHC
Species Reactivity: Human
-
-
-
-
-